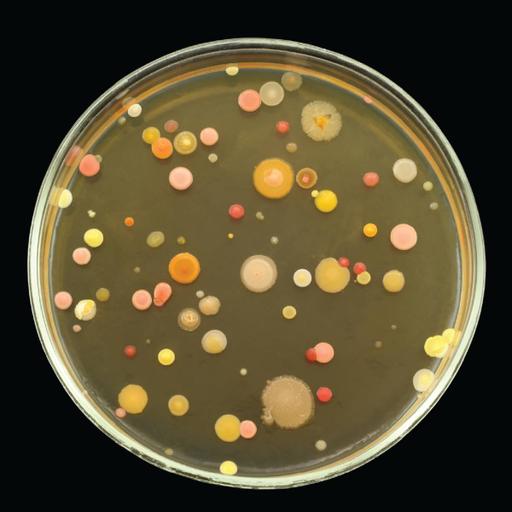
Picture of the product

Food Hygiene & Sanitation
Food can act as a medium for growth and reproduction of disease causing pathogens. It helps in transmitting pathogens like bacteria, virus or other parasites which can cause illness or a severe disease outbreak. It can adversely affect both human beings and animals and lead to severe conditions. Therefore it is important to take good care of the hygiene and sanitation of food processing laboratories. It is essential to have a balanced diet with proper nutritive food which keeps human fit. Food provides energy to keep on moving, like a vehicle needs fuel. By properly maintaining the hygiene, we can prevent food poisoning to a greater extent. To control the overall health of a human being, he or she must include healthy meal in their diet. It is important to have adequate supply of water to body organs and tissues. Water, vitamins, minerals, fats and carbohydrates are the essential nutrients to keep a healthy balanced diet.